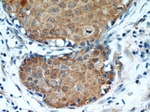
Oxytocin Receptor Antibody in Immunohistochemistry (Paraffin) (IHC (P))

Search
Proteintech
Oxytocin Receptor Polyclonal Antibody
{{$productOrderCtrl.translations['antibody.pdp.commerceCard.promotion.promotions']}}
{{$productOrderCtrl.translations['antibody.pdp.commerceCard.promotion.viewpromo']}}
{{$productOrderCtrl.translations['antibody.pdp.commerceCard.promotion.promocode']}}: {{promo.promoCode}} {{promo.promoTitle}} {{promo.promoDescription}}. {{$productOrderCtrl.translations['antibody.pdp.commerceCard.promotion.learnmore']}}
产品信息
23045-1-AP
种属反应
已发表种属
宿主/亚型
分类
类型
抗原
偶联物
形式
浓度
规格
纯化类型
保存液
内含物
保存条件
运输条件
产品详细信息
This antibody is raised against the C-terminal region of human OXTR.
Immunogen sequence: PWIYMLFTG HLFHELVQRF LCCSASYLKG RRLGETSASK KSNSSSFVLS HRSSSQRSCS QPSTA (326-389 aa encoded by BC137443)
靶标信息
The oxytocin receptor (OXTR) belongs to the G-protein coupled receptor family. Its activity is mediated by G proteins which activate a phosphatidylinositol-calcium second messenger system. The receptor is made up of 389 amino acids and has a molecular weight of ~43,000 kDa. The oxytocin-oxytocin receptor system plays an important role as an inducer of uterine contractions during parturition and of milk ejection. Oxytocin receptors are expressed by the myoepithelial cells of the mammary gland, and in both the myometrium and endometrium or the uterus at the end of pregnancy. Additionally, oxytocin receptors are present in the central nervous system, mediating a variety of behaviors, including maternal behavior, bonding, social memory and recognition, sexual and aggressive behaviors, and stress and anxiety.
仅用于科研。不用于诊断过程。未经明确授权不得转售。
生物信息学
蛋白别名: G-protein coupled receptor; OT-R; Oxt-r; Oxytocin receptor; unnamed protein product
基因别名: OT-R; OTR; OXTR
UniProt ID: (Human) P30559
Entrez Gene ID: (Human) 5021